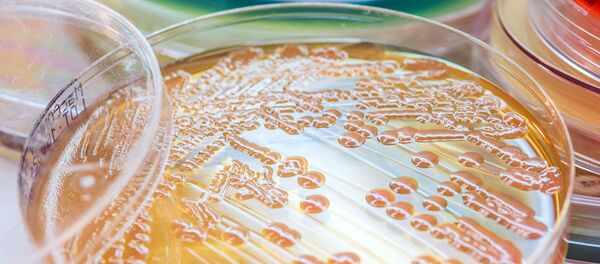
俄罗斯学者们制造出灭杀98%细菌的移植材料 俄罗斯学者们制造出灭杀98%细菌的移植材料 - 俄罗斯卫星通讯社

在这种材料的基础上,可以制造多种医学、航天航空制造和其它领域的多种微型装置。研究成果发表在《材料》(Materials)杂志上。
专家们指出,所获合金属于“智能”材料,具有形状记忆和超弹性的效果,在大变形(高达14%)后加热时能够恢复形状。
借助于从液态和超塑(强烈)变形中超快冷却的混合极端作用,成功获得了独特材料。
以这种方式在极限状态下制造出的材料是材料学的最新成就。它在机器人技术、航空航天科技、能源、仪器制造、生物医学和生物科技领域都有着广泛的应用。
“由于以溶液每秒大约冷却一百万度的速度超快淬火,从TiNi-TiCu合金中获得了含铜量高的、金属玻璃状的无定形带材,其厚度在30到50微米之间”,——俄罗斯国立核研究大学莫斯科物理工程学院“固体物理学和纳米系统”系副教授亚历山大·舍利亚科夫评论说。
所获得的轻薄快速淬火带材是制造微型速动装置的相当富有前景的材料。
学者们认为,这开辟了开发创新实用材料的可能性,有助于为微型生物科技或微(纳米)电子机械系统科技制造出一整套的微型装置——微型钳子、微型阀门、微型夹子、微型传动装置。

京公网安备11010502053235号